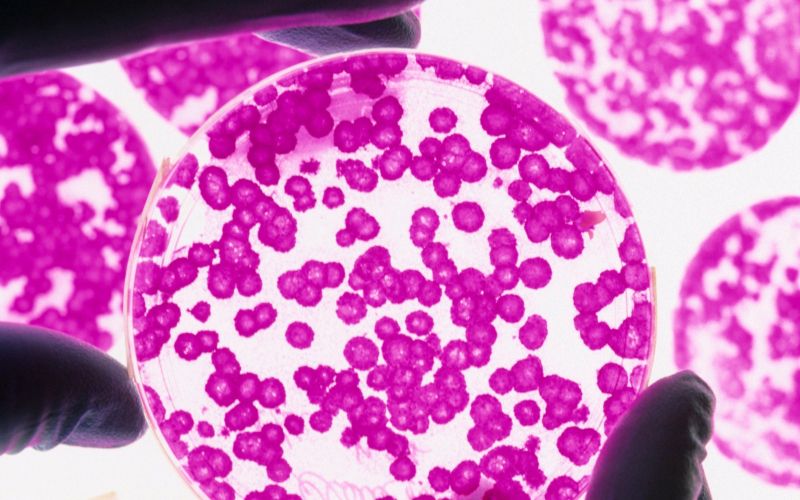

Najnovejše


Življenje je dolgočasno, če v njem ni boja
Najprej smo hoteli izbrati samo eno sličico s svetovnega prvenstva v nogometu za ženske, pa ni šlo. Kar same so se ponujale, in potem smo končno dojeli: seveda, ženski nogomet je samo še ena metafora za življenje. In vse dogajanje na prvenstvu odlično povzame pušeljc slovenskih pregovorov. Čeprav nas na prvenstvu sploh ni bilo zraven.

V deželi letečih slonov
Kraj: obrobje Ljubljane Čas: junijska sobota, ko 90 odstotkov nacije stoji v zastojih na primorki, preostali za spuščenimi roletami namakajo noge v lavorju, v gozdu pa sva očitno samo jaz in telefon.

V Bih operacija proti pranju denarja: blokirali račune, na katerih je bilo kar 200.000 evrov
Pripadniki preiskovalne in varnostne agencije BiH (Sipa) in policije Federacije BiH so v okviru mednarodne policijske operacije Balkanski kartel blokirali račune osumljenih nezakonitih denarnih transakcij in pranja denarja. Na računih je bilo približno 200.000 evrov. Zasegli so tudi dragocene avtomobile, poročajo mediji v BiH.

Tinkara Kovač o zmagovalni pesmi
Na sobotnem festivalu Melodije morja in sonca je že drugič v svoji karieri slavila Tinkara Kovač. Prvič ji je to uspelo s pesmijo Mars in Venera leta 2013, k sta za njeno pesem poskrbela zakonca Lea Sirk in Gaber Radojevič. Tokrat pa je prepričala s pesmijo Bodi z mano do konca, ki je nastala izpod rok Aleša Klinarja.

Mihalinčeva in Horvatova šesti, rekord Lukanove na Madžarskem
Maja Mihalinec je bila šesta na atletskem mitingu Istvan Memorial na Madžarskem v teku na 200 m (23,18), to mesto pa je v teku na 400 m dosegla tudi Anita Horvat, ki je na 400 m dosegla svoj najboljši čas sezone (52,51).

Anže Kopitar ISKRENO: Super, da bomo IGRALI DOMA. In da se ne bo slišalo le TELEFONOV!
Slovenski hokejski as Anže Kopitar se veseli dejstva, da bo naslednjo svetovno prvenstvo divizije I v Sloveniji. Reprezentanci bo na razpolago, če bodo klubske obveznosti to dovoljevale, sicer pa je prepričan, da so možnosti za vrnitev Slovenije med elito vedno dobre.

S preprostimi vajami do popolne sproščenosti
Predstavljamo vam znanstveno potrjeno tehniko, ki pomaga pri sproščanju telesa in duha. Da bi se je naučili, potrebujemo miren prostor, udobno ležišče ter nekaj potrpežljivosti.

Podravje: V sistem šolske prehrane vključiti več lokalne in ekološke hrane
Po vzoru šolske sheme, ki v Sloveniji uspešno teče, saj jo izvaja 90 odstotkov šol, naj bi otroci v šolah tudi sicer jedli lokalno pridelano kakovostno hrano. Država naj bi zato izboljšala sistem javnega naročanja, nad katerim se pritožujejo lokalni dobavitelji.

Slovenija: Žetev in cena pšenice
Če se v prihodnje odkupna cena pšenice ne bo zvišala, se bodo najbrž mnogi kmetje preusmerili v pridelavo pivovarskega ječmena. Trgovci nimajo interesa za domačo pšenico.

Ptuj: Dva stara in ena nova ravnateljica
Kljub zapletom, ki so spremljali razpisni postopek, je s soglasjem ministrstva za izobraževanje, znanost in šport izbira dveh ravnateljev srednjih šol, Strojne šole ŠC Ptuj ter Elektro in računalniške šole Ptuj, dokončna. V drugo je bila z veliko večino glasov izbrana tudi stara nova ravnateljica Ekonomske šole Darja Harb. Vse čaka veliko dela, saj se zavod srečuje z upadom vpisa dijakov in finančnimi težavami, ki jih bo letos ponovno reševalo ministrstvo za izobraževanje.

Kidričevo, Strnišče: Območje že degradirano, v prihodnje bo še bolj
Kidričevo se je v minulih 60 letih, odkar je v kraju vrata odprla tovarna glinice in aluminija, danes Talum, razvijalo kot industrijsko območje. Tovarna je skozi desetletja dajala kruh več generacijam delavcev.

Župani: »Naj se gradnja prvega dela ceste Ptuj-Ormož že začne!«
Župani v Spodnjem Podravju so nezadovoljni s sedanjim tempom postopkov v zvezi z gradnjo ceste Ptuj–Ormož. Želijo, da se zadeve pospešijo in da se začne etapna gradnja; torej da bi se čimprej lotili izgradnje prvega odseka ceste od Ormoža do Gorišnice, za katerega imajo pridobljeno gradbeno dovoljenje.

Ormož : Cesta z veliko pomanjkljivostmi
Pred približno petimi leti je Komunalno podjetje Ormož moderniziralo lokalno cesto na Kogu v vrednosti nekaj več kot pol milijona evrov. Drago investicijo pa si bomo očitno zapomnili tudi po številnih pomanjkljivostih, saj domačini opozarjajo na razpoke, posedene jaške, razraščeno travo med robniki in asfaltirano površino …

Hajdina: Konec načrtov za širitev kartodroma?
Konec junija je bil na Hajdini sprejet občinski prostorski načrt (OPN). S tem bo omogočena novogradnja številnih objektov, prinaša pa ta dokument tudi nekatere omejitve, predvsem z vidika varstva okolja in prostorske ureditve. Je s to potezo preprečena tudi širitev kartodroma v Slovenji vasi? Omejitve ministrstva za okolje in prostor si očitno vsak razlaga po svoje ...

Markovci: Drava spodjeda jez
Dravske elektrarne Maribor (DEM) so sredi junija na Dravi pod jezom v Markovcih odprle gradbišče.

Trikrat poročena, a nikoli zaljubljena
Whoopi Goldberg, ki je po zakonskih vodah plula s tremi različnimi moškimi, je priznala, da pravzaprav v nikogar od njih ni bila resnično zaljubljena.

Umor na CSD-ju: Andrija se je skrival v zapuščeni staji, policisti pa so mu že nadeli lisice
Hrvaški policisti so sporočili, da so aretirali 59-letnega moškega, ki je nekaj minut po poldnevu v Centru za socialno delo v Đakovu na Hrvaškem pokončal uslužbenko Blaženko Poplašen (50) in ranil pravnika omenjenega centra Ivana Pavića(35).

Radijska voditeljica o gostu, ki jo je spravil v jok
V tej sezoni je radijski voditeljici na Radiu 2 Evi Cimbola najbolj ostal v spominu intervju z mojstrom tatujev, ko se je tudi sama pošteno zjokala v eter.

Kdo si sploh lahko privošči dopust in kam najraje gremo?
Zasebno potovanje si lahko privošči sedem od desetih Slovencev, pri čemer sta bila med najpogostejšimi razlogi za odhod na počitnice sprostitev in počitek.

Tajni poklon princesi Diani
Minuli vikend sta Meghan Markle in princ Harry za zaprtimi vrati krstila svojega prvorojenca Archieja Harrisona, krsta pa sta se med drugim udeležila tudi princ William in Kate Middleton, ki se je na ta dan spomnila pokojne Diane.

Kje in kako letos dopustuje Rebeka Dremelj?
Družina si je tudi letos privoščila luksuzne počitnice. Vas zanima, kam so jo mahnili?


Skupne patrulje le alibi za postavitev fizične meje med Italijo in Slovenijo
Premier Marjan Šarec in slovenska politika še vedno trdita, da je naša južna meja dobro varovana in da ni nobene potrebe po ograji na slovensko-italijanski meji, saj bodo skupne patrulje slovenskih in italijanskih policistov zadostovale. Poznavalci pa trdijo, da bodo rezultati skupnih patrulj zgolj dali alibi za postavitev fizične meje med državama.

Nova sezona, STARI RAZLOG za jezo!?! Mariborčanom bo sodil LJUBLJANČAN, Olimpiji pa …
Znani so sodniki za tekme prvega kroga PLTS.

FOTO: Krajani obupujejo zaradi smradu in onesnaženja
Vaščane Sodincev v občini Ormož jezijo neprijetne vonjave in odplake, ki se širijo iz tamkajšnje slabo delujoče rastlinske čistilne naprave. Odločeni so, da nočejo več čistilne naprave pred hišnimi pragovi, in zahtevajo, da se prestavi na primernejšo lokacijo, na kar so sicer opozarjali že pred njeno gradnjo.

NOŽ V MANDARIĆEVO SRCE! Bivši zvezdnik Olimpije UDARIL: Njegov odhod bo DOBRA STVAR, saj ...
Ricardo Alves ni pozabil Olimpije. Niti Milana Mandarića ...

So lovske kamere na Goričkem posnele šakale?
Aprila so v lovskem revirju pri Beznovcih našli šakalja mladiča, zadnjo julijsko nedeljo in že prej v mesecu maju pa so kamere na prežah Lovske družine (LD) Cankova v istem revirju posnele živali, ki so vsaj zelo podobne šakalom.

“Pavle, prosim te, zbudi se” je ihtel oče, potem ko je njegovega sina ubila strela; umrl je na njegovih rokah
Nedeljska neurja so prizadela tudi srbske prebivalce. Strela pa je v naselju Skrobara pri Pančevu ubila sedemletnika in Perici Gavazoviću vzela sina Pavla, piše Kurir.

Williamsova dvanajstič, Halepova drugič, Strycova in Svitolina prvič v polfinalu Wimbledona
Na teniškem turnirju v Wimbledonu sta že znana ženska polfinalna para. Sedemkratna zmagovalka turnirja, Američanka Serena Williams, se bo v četrtek pomerila s Čehinjo Barbaro Strycovo, Romunka Simona Halep pa z Ukrajinko Jelino Svitolino.

Bizovičar za dopust spakiral do vrha poln avto
Zdi se, da mu dopustniško pakiranje ni kaj preveč všeč …

»To je trdo delo in garanje!«
Lepa, inteligentna in dobrosrčna. To so le tri lastnosti, s katerimi bi lahko opisala trenutno najbolj iskano umetnico lepotnega ličenja pri nas, Dorotejo Premužič.


Predlog novele zakona o financiranju šolstva podpira zgolj tretjina poslancev
Sprejetje novele zakona o organizaciji in financiranju vzgoje in izobraževanja, s katero naj bi uresničili ustavno odločbo glede financiranja zasebnih šol, je negotovo. Tudi v koaliciji enotne podpore ni, saj SMC predloga ne bo podprla. Po njenem mnenju ne uresničuje ustavne odločbe, je povedal poslanec Igor Zorčič. Levica in SNS se še ne izrekata.


Vivianiju sprint v Nancyju, Mohorič 14.
Italijanski kolesar Elia Viviani je zmagal v sprintu četrte etape dirke po Franciji. Po 213,5 kilometra je zvezdnik Deceuninck - Quick Stepa v Nancyju prehitel Norvežana Alexandra Kristoffa in Avstralca Caleba Ewana. Moštveni kolega Vivianija Francoz Julian Alaphilippe je obdržal rumeno majico vodilnega.

Znani Slovenci obkroženi z levi
Igralci, ki so sinhronizirali Levjega kralja, so v živalskem vrtu obiskali leve, surikate in svinje.

Tara Zupančič - Lepotica z boemsko dušo
Zgovorna lepotica, ki jo v zadnjem času poznamo predvsem kot voditeljico pravkar končane tretje sezone šova Zvezde plešejo, je tudi velika ljubiteljica mode. Ne samo da je bila nekoč manekenka, rada se uredi, najpogosteje v tako imenovanem boho stilu, ki se sklada z njeno osebnostjo – na znotraj plaha in zadržana, na zunaj samozavestna in odločna.

Znana starleta pokazala prijateljico: “Imata istega plastičnega kirurga?”
“Kdo je prijateljica? Videti sta kot dvojčici!” so glasili komentarji pod instagram objavo Soraje Vučelić, srbske starlete. Fotografija je v manj kot treh urah zbrala več kot 3.000 všečkov, sedaj pa jih šteje že več kot 10.000.

Hajdinjak in Cenerjeva zmagovalca poletnega turnirja
Športno rekreacijsko društvo (ŠRD) Gornji Slaveči je pripravilo četrti tradicionalni poletni pikado turnir. Sodelovalo je 65 igralcev in igralk pikada.

Iračan, ki je napadel taksista, po operaciji že pred sodnika
Iračana, ki je v nedeljo zvečer napadel in porezal taksista ter kasneje napadel še policista, so s kazensko ovadbo danes ob 16. uri pripeljali pred preiskovalnega sodnika novogoriškega okrožnega sodišča.

Evropska unija pozvala Iran, naj ne krši jedrskega sporazuma
Evropska unija je danes pozvala Iran, naj zaustavi vse aktivnosti, ki niso v skladu z omejitvami in zavezami v okviru iranskega jedrskega sporazuma (JCPoA). EU namreč še vedno ostaja zavezana sporazumu, ki je ključnega pomena za varnost regije in širše.

Katera se je Denisu zapisala v srce?
Tekmovalec šova Zvezde plešejo oboževalce presenetil z novo pesmijo.


Halepova in Williamsova prvi polfinalistki Wimbledona
Znani sta prvi polfinalistki Wimbledona.

V Kromberku zbil mladoletnega pešca in nato zbežal
Na lokalni cesti izven naselja Kromberk pri Novi Gorici je v ponedeljek zvečer nekaj po 20.20 voznik osebnega vozila zbil mladoletnega pešca.

FOTO: Izgubljeni ježek taval pred UKC-jem, sedaj pa ima nov dom in novo ime
V parku pred Univerzitetnim kliničnim centrom v Ljubljani se je že drugi dan med avtomobili potikal izgubljeni ježek. Danes pa je bil zanj srečen dan.


Po zdravje na Bled
Že sredi 19. stoletja je naš naravni biser postal prepoznan tudi zaradi zdravilnih terapij Arnolda Riklija.


ZLATI FANT iz Partizana v Stožice? Za Nikolića v boj tudi NEKDANJI EVROPSKI PRVAK
Slovenski reprezentant Aleksej Nikolić je eden od kandidatov za dres novoustanovljene Cedevite Olimpije, a ima tudi druge ponudbe.

Capin nesramni, vrni ukradeni avto in otroški voziček za dvojčke
Osebek brez spoštovanja do tuje lastnine je izpred bloka za Bežigradom ukradel avtomobil.

EVERTON pripeljal SLOVENCA! Preizkušala ga je BARCELONA, izbral je Anglijo
Slovenci imamo novega nogometaša pri klubu iz angleške premier lige.

Deložacija Hotela Diana spet prestavljena
Jutri bi moralo priti do izpraznitve prostorov hotela v središču Murske Sobote, ki jih uporablja družba Hotel Diana, vendar je bila deložacija spet prestavljena.

Pred stoletjem obelodanili, kam spada Prekmurje
Devetega julija mineva natanko sto let, kar je bila podpisana versajska pogodba, s katero so odločili in obelodanili, da Prekmurje pripade h Kraljevini Srbov, Hrvatov in Slovencev. Za to so posebno zaslužne tudi takratne velesile Velika Britanije, ZDA, Francija, Italija in Japonska. Visoki predstavniki vseh teh držav so se danes zbrali v Murki Soboti.

Šimundža: "Ne gremo se branit, to bi bila smrtna obsodba"
Pred odhodom v Izrael na prvo srečanje kvalifikacij Lige Evropa z Maccabijem iz Hajfe so pri Muri pripravili novinarsko konferenco s trenerjem Antejem Šimundžo in kapetanom Alenom Kozarjem.

Štajerski prijatelji, IZVOLITE! Maribor sosednjemu klubu ODSTOPIL KAR TRI nogometaše
Novi odhodi pri Mariboru.


UČITELJ, da te kap: Pomočniku trenerja Triglava svetoval eden najuglednejših NA SVETU! (foto)
Pomočnik trenerja Triglava v zelo znani družbi.

Stol, ki je Slovenijo postavil na oblikovalski zemljevid
Če še niste slišali za slovenskega arhitekta, univerzitetnega profesorja in industrijskega oblikovalca Nika Kralja, pa ste zagotovo že slišali za katero izmed njegovih ikoničnih del v oblikovanju, zaradi katerih je postal poznan tudi drugod po svetu.

Lenoba in telesna kondicija? Lahko gresta z roko v roki!
Poletje se res hitro bliža in vse, ki se do zdaj nismo kaj prida ukvarjali s fizično aktivnostjo, je začela peči vest. A roko na srce, človeku brez kondicije in volje je težko dopovedati, da bo z danes na jutri treba ure in ure dvigati uteži ali se potiti na tekaški stezi, z občutkom srca v grlu. Dobra novica pri tem je, da je vsako razgibavanje, tudi če vanj vložimo kar najmanjšo količino truda, bolje kot to, da smo popolnoma neaktivni. Tu je nekaj nasvetov, kako telo prebuditi, tudi če nam že sama misel na telovadbo dela preglavice.

Zagotovite si povračilo denarja za zobozdravstvene storitve v Zagrebu. Prihranki do več tisoč evrov
Čakalne dobe v zobozdravstvu so najpogostejši razlog za samoplačniško oskrbo zob, tudi na Hrvaškem. Pacienti pa so le redko seznanjeni s pravicami, postopkom in storitvami, za katere jim, v primeru zdravljenja v tujini, pripada povračilo denarja.

Pri sosedih Andrija streljal na uslužbence centra za socialno delo, ugasnilo eno življenje, za drugega se še borijo
Ubita je bila uslužbenka tamkajšnjega centra za socialno delo, njen sodelavec pa je hudo ranjen.

Zahović NAŠEL NOVEGA: Maribor pripeljal NAJSTNIKA, ki je takoj dobil PROFESIONALNO pogodbo!
Nov podpis profesionalne pogodbe v Mariboru.

FOTO in VIDEO: Ulice kot deroče reke in avtomobili kot nemočne barčice
Vreme ni divjalo le pri nas. V Španiji so poplave, ki so po nenadnem hudourniškem deževju danes prizadele pokrajino Navarra na severu države, zahtevale smrtno žrtev.

FOTO in VIDEO: Pri Velikih Laščah na ceste plugi, v Kočevju uničujoč veter, danes na udaru Primorska?
Besa narave sta bili včeraj deležni osrednja in južna Slovenija. Vreme je postreglo s silovitim neurjem in točo. Na območju Velikih Lašč so denimo aktivirali celo plužno službo, toča pa je precej poškodovala poljščine in vrtnine. Danes podobno preti jugozahodu države.


Šarec: De facto schengen danes ne deluje več
Razlogov, da bi Italija na meji s Slovenijo postavila ograjo, ni, kar kažejo tudi podatki, je na današnji seji državnega zbora zagotovil Marjan Šarec.



Tudi Pomgrad bo pomagal Muri
Mura je po družbi GMT in zavarovalnici Generali dobila še tretjega glavnega sponzorja.

Kdo potrebuje drage izdelke, če imate doma sodo bikarbono!
Sodo bikarbono zagotovo uporabljate pri peki. Morda pa ne veste, da je tudi zelo učinkovito, a hkrati nežno čistilno sredstvo in odličen naravni deodorant.

Na mladino med počitnicami prežijo spletne pasti
Mladi že uživajo v poletnih počitnicah, mnogi se zabavajo na spletu, kjer pa jih čaka nemalo pasti. Seznanite se z nasveti za varno rabo interneta med počitnicami, ki jih je za vas pripravil Marko Puschner iz Točke osveščanja o varni rabi interneta Safe.si.

Nekdanji zvezdnik Liverpoola OBUPAN: Poslušajte, dam vam 33 tisoč evrov, samo ...
Zdaj že nekdanji zvezdnik Liverpoola ima za seboj grozljivo izkušnjo.

Legendarni Radović POVSEM SKRUŠEN! Bivši član Olimpije priznal: BOLI ME SRCE, želel sem si le …
Miroslav Radović je ostal brez kluba.


Romun tihotapil plin za klime
Uslužbenci finančne uprave so na postajališču Pince zasegli jeklenke s hladilnim plinom za klimatske naprave.

SRAMOTNO: Otroci stali in gledali, starši na tribunah pa se pretepali! Prizor šokira, vse se je začelo z ... (video)
Prizor, nad katerim se zgraža širša javnost.

Dogovor o cenah pšenice: Žagajo si vejo, na kateri sedijo
Slovenske predelovalne industrije ne zanima samooskrba. Mlinarji igrajo svojo cenovno igro.


Več kot 230 aretacij v mednarodni protidopinški raciji, vpletena tudi Slovenija
V veliki protidopinški raciji so evropski varnostni organi v 33 državah, tudi Sloveniji, ukrepali proti posedovanju anabolnih steroidov in ponarejanju zdravil, poroča STA.


Ali je to FOTOŠOP?! Poglejte, kaj je Luka Dončić naredil iz SEBE, družabna omrežja GORIJO! (foto)
Luka Dončić uživa na dopustu.


Zdaj ni več nobenih dvomov, Muri bo v Izraelu ZELO TEŽKO: Na prvo gostovanje kar BREZ ŠTIRIH!
Že nekaj časa je jasno, da bo Mura v četrtkovem obračunu prvega kroga kvalifikacij za ligo Europa z Maccabijem zelo oslabljena.

Bela oblačila niso primerna zaščita pred soncem!
Morda temu doslej niste posvečali pozornosti, a pomembno vlogo pri zaščiti pred soncem ima tudi barva oblačil.


Muguruza se je razšla z dolgoletnim trenerjem
Španska teniška igralka Garbine Muguruza, dvakratna zmagovalka turnirja velike četverice, je prekinila sodelovanje z dolgoletnim trenerjem, Francozom Samom Sumykom. Do razhoda je prišlo teden dni po tem, ko je trenutno 27. igralka sveta na turnirju v Wimbledonu izpadla v prvem krogu.

Izvedenka klinične psihologije o vzgojiteljici Franki, obtoženi surovega ravnanja z otroki
Tožilstvo nekdanji vzgojiteljici Franki Kovačič očita, da je od začetka leta 2013 do poleti 2015 surovo ravnala z 18 malčki.

(FOTO) Bodoči ženin je izvedel začetni udarec
Potem, ko je ugrabitev neveste zaznamovala tekmo Mure, je prijateljsko tekmo v Beltincih popestrila fantovščina.

FOTO: Med bliskovito nevihto na Ptuju "zmlelo" skoraj 300 ptic
Bliskovit nedeljski naliv je na Ptuju presenetil tudi živali.


Skoraj bi jima SPET USPELO: Dekle s finala lige prvakov razkrila spodletel načrt z zadnjega spektakla! (foto)
Kinsey Wolanski je dekle, ki so ga mnogi lahko bolje spoznali med letošnjim finalom lige prvakov.


Agencija Telemachu odvzela del frekvenc za mobilno telefonijo
Agencija za komunikacijska omrežja in storitve RS (Akos) je razjezila družbo Telemach. Odvzeli so jim del frekvenc za mobilno telefonijo, ki jih je Telemach pridobil s prevzemom Tušmobila. Telemach je zoper odločbo vložil tožbo.

Prvič v Križankah: kralj romantičnih balad, Saša Matić!
Po razprodani Areni Zagreb, tudi Slovence čaka magična noč kralja najlepših balad na Balkanu, Saše Matića, ki bo v nedeljo, 15. septembra 2019 v ljubljanskih Križankah.

Prvič v Križankah: kralj romantičnih balad, Saša Matić!
Po razprodani Areni Zagreb, tudi Slovence čaka magična noč kralja najlepših balad na Balkanu, Saše Matića, ki bo v nedeljo, 15. septembra 2019 v ljubljanskih Križankah.

Prvič v Križankah: kralj romantičnih balad, Saša Matić!
Po razprodani Areni Zagreb, tudi Slovence čaka magična noč kralja najlepših balad na Balkanu, Saše Matića, ki bo v nedeljo, 15. septembra 2019 v ljubljanskih Križankah.

Igralka ga je obtožila, da jo je posilil – z očmi
Zasluži si, da zgnije, je zapisala.


Konec sveta v živo
Ravno ko se je jedrska nezgoda v Černobilu leta 1986 začela odmikati in počasi bledeti v spominu, je prišla HBO-jeva miniserija Černobil in ne le obrisala radioaktivni prah z več kot tri desetletja stare tragedije, temveč vzbudila toliko zanimanja, da je na noge postavila novo vejo turizma, »jedrski turizem« – ker se očitno nič ni zares zgodilo, če tam ne narediš selfija.

PSG je OBUPAL, iz kluba prihaja tole SPOROČILO: Neymar lahko odide ...
Neymarju vodilni možje PSG-ja ne bodo nagajali.

Američani za informacije o teh treh Slovencih ponujajo 15 milijonov dolarjev nagrade
ZDA so za informacije o Mihaelu Karnerju, Alenki Karner in Matevžu Karnerja razpisale 15 milijonov dolarjev nagrade.

Postanite pravi mojster!
Poletni čas kar kliče k druženju na prostem, ko v sončnem vremenu posežemo po dobrotah z žara in ohlajeni pijači ter se v družbi prijateljev predajamo toplim sončnim žarkom. Kako postati dober gostitelj in še boljši žar mojster?


Kar zmore OLIMPIJA, zmorejo tudi DRAGONSI! Posebna AKCIJA NAVIJAČEV, pred evropsko tekmo se bo …
V četrtek se v Stožicah obeta pestro dogajanje.

Akupunktura med nosečnostjo – da ali ne?
Zadnja leta se v Sloveniji čedalje več nosečnic odloča za akupunkturo za lajšanje nekaterih tegob. Vendar pa je dobro vedeti, kdaj se ta v nosečnosti priporoča, pri kakšnih težavah in v katerem delu tromesečja. Akupunktura vsekakor blagodejno vpliva na živčevje in spodbudi cirkulacijo, s tem pa lahko pomaga tudi pri spodbuditvi popadkov, če se sami ne začnejo. V medijih se večinoma piše le o pozitivnih učinkih, vendar pa je dobro vedeti, da lahko pri neizkušenem zdravniku dobimo tudi učinek, ki si ga ne želimo. Kako je torej s tem?

Plavalec postal VELIKI JUNAK! Rešil utapljajočega moškega in RAZKRIL srhljive podrobnosti: Ko sem prišel do njega ...
Nekdanji vrhunski italijanski plavalec Filippo Magnino je na obali Sardinije rešil moškega, ki se je utapljal. Nekdanji svetovni prvak je skočil v vodo, potem ko so prijatelji utapljajočega vpili, da se utaplja.



Pri Ptuju zaradi neurja poginilo okoli tristo galebov
"Neurje nad Ptujem in okolico ni bilo katastrofalno le za ljudi, temveč tudi za živali," pravijo pri Društvu za opazovanje in proučevanje ptic Slovenije.

Za kaj več bi bil potreben čudež
Bolgarska Alabena, ki jo domačini imajo za najprestižnejši turistični kraj na Črnem morju, je gostila evropski reprezentančni turnir za kadete v hokeju na travi, ki so se ga udeležili tudi slovenski predstavniki.

Šok po porodu, pričakovala dvojčici, a je rodila »napačna« otroka
Pričakovala sta dvojčici, povila pa dva dečka, ki sta ju morala nato predati biološkim staršem.

Ryan Lochte: Drugič očka
V nedeljo, 16. junija, so v ZDA praznovali očetovski dan, le dan pozneje pa se je sloviti plavalec Ryan Lochte razveselil svojega drugega otroka.

Kaj se dogaja pri Hafnerjih? Je Ana že rodila?
Ana Podobnik je imela predvideni datum poroda 2. julija, torej po zaključku televizijskega predvajanja priljubljenega šova Ljubezen po domače.

Španec s ČUDOVITO GESTO stopil SRCA: Njegov soigralec UMIRA, on pa je storil nekaj, kar … (foto)
Čudovita poteza španskega nogometaša.

Neizmerna tragedija: umrla je štiriletnica, ki jo je oče pustil v razbeljenem avtomobilu
"Zakaj sem to storil, kako sem jo lahko pustil tam," je v četrtek ihtel 33-letni oče štiriletnice. Danes je nesrečnica umrla.

STRUPENA in NAGAJIVA: Dončićeva Anamaria SEKSI kot hudič, cedila se vam bo SLINA! (foto)
Izbranka slovenskega košarkarskega zvezdnika se vse bolj uveljavlja v svetu mode.

UF, SARMA! Novi trener Interja CONTE vodil prvi trening - kar je naredil SLOVENCU, odmeva! (foto)
Inter je začel s pripravami v švicarskem jezersko-alpskem biseru Luganu.

FOTO: Skupaj z njo zapeljal pred vlak, ker se je selila v Monako? Za seboj sta pustila tri majhne otroke
Zaenkrat še ni znano, zakaj je ravnal, kot je. Preiskava še poteka.

Slovenske gorice: Pogrešajo 14-letnega Žana
Policijska uprava Maribor sporoča, da iščejo 14-letnega Žana Simončiča iz okolice Lenarta.

Fužinar z ODMEVNO OKREPITVIJO! Drugoligaš močnejši v NAPADU, vrnil se je IZGUBLJENI SIN
Tadej Trdina bo spet igral na Koroškem.

Iz OLIMPIJE v KOPER! V prestolnici za REPREZENTANTA ni bilo več prostora, preselil se je na OBALO!
V Kopru so dodatno okrepili ekipo.

Slovenski tenisač in blogerka dahnila usodni da
V začetku leta sta se razveselila prvega otroka, zdaj je napočil čas še za poroko.

Neymar UDARIL po PSG-ju: Laži in sprenevedanje! Da niso vedeli za to?! To je VSA RESNICA!
Zakaj se Neymar ni udeležil prvega treninga PSG-ja?

Sredstva za rekonstrukcijo varovanega oddelka v Domu Lukavci zagotovljena
MDDSZ bo v letu 2019 zagotovilo sredstva v višini 800.000,00 evrov za širitev kapacitete v posebnem socialnovarstvenem zavodu Dom Lukavci.



OSLABLJENI! Maribor odpotoval na Islandijo, doma ostali TRIJE nogometaši, tudi NAJBOLJŠI!
Maribor se je odpravil na sever Evrope.

Erica je soproga pomotoma ustrelila v glavo
Prepir na avtocesti v bližini Dodge Citya v ameriški zvezni državi Kansas se je končal s strelom v napačno tarčo.


FOTO: Na Gradiščanskem voznik s polno hitrostjo v hišo in smrt
Brez zaviranja je trčil naravnost v hišo. Ni mu bilo pomoči.

FOTO: Ian Thorpe se je razšel s fantom. To naj bi bil razlog
Olimpijski plavalec je bil opažen danes zjutraj. Po novem je samski.


Indira Ekić delila utrinek s poroke
Blestela je v kratki oranžni obleki in svojemu izbrancu namenila prelepe besede.

FOTO in VIDEO: Od Brezovice do Vinice: ledene kroglice neusmiljeno klestile po pridelku, veter pa odkrival strehe
Z današnjim dnem se končuje nevihtno obdobje, ki je postreglo z uničujočimi neurji s točo.

Italijani ŽE V MADRIDU: To je naslednji zvezdnik Reala, ki zapušča Santiago Bernabeu!
Španski mediji trdijo, da je James Rodriguez na pragu prestopa k Napoliju.

Irina Shayk: Zadovoljna z zadnjima dvema letoma
Po mnenju ruske manekenke Irine Shayk se je modna industrija za starejše ženske spremenila, in to v pozitivnem smislu.


Korak k rešitvi iz krize? Maduro spravljivo, Guaido išče pravno podlago za vojaško posredovanje
Venezuelski predsednik Nicolas Maduro je v ponedeljek izrazil optimizem ob začetku novega kroga pogajanj z opozicijo v Barbadosu.


(FOTO) Na negovskem gradu odprli razstave priznanih fotografov
Foto klub Proportio Divina Gornja Radgona je v sodelovanju s Fotografsko zvezo Slovenije in Zavodom za kulturo, turizem in promocijo Gornja Radgona pripravil odprtje treh odličnih fotografskih razstav v sklopu Fotogradu Negova 2019 - jesen. Tokrat se na Gradu Negova s svojimi deli predstavljajo Virgilio Bardossi (Maramures), Igor Dutina (Povolilna tišina) in Manolis Metzakis (El Greco).

Vpletena tudi SLOVENIJA! Po Evropi več kot 230 aretacij, to je bila največja operacija do zdaj!
V veliki protidopinški raciji so evropski varnostni organi v 33 državah, tudi Sloveniji, ukrepali proti posedovanju anabolnih steroidov in ponarejanju zdravil. Preiskovalci so opravili tako imenovano "največjo operacijo take vrste", poimenovano operacija Viribus, je Evropski policijski urad (Europol) objavil v ponedeljek.


Tihi ubijalec stres in 13 rešitev
Po podatkih svetovne zdravstvene organizacije so stres, tesnobnost (anksioznost) ter depresija ene večjih zdravju škodljivih nevarnosti 21. stoletja. Že vsak tretji je domnevno nenehno v stresu. Da, tudi pri nas!

O dveh revijah in o Mateju s krokodilom (ali brez njega)
Zgodba, ki vam jo želim povedati danes na tem mestu, je stara skoraj kot večnost.


Elizabeta II. naj bi čez dve leti predala vajeti
Tako pravijo poznavalci razmer na britanskem dvoru.

Dajmo se fantje zresnit
Na prste ene roke štorastega mizarja bi lahko preštel prijatelje, kolege in znance, ki se obnašajo vedno bolj častitljivim letom primerno, torej kot odrasli in odgovorni moški.



Z modificiranimi komarji bi lahko premagali malarijo
Za nas so komarji zoprna poletna nadloga, za precejšen del svetovnega prebivalstva pa velika grožnja, saj širijo smrtonosne bolezni, kot je malarija. Znanstveniki se že vrsto let ukvarjajo s tem, kako bi rešili težavo in s tem številna življenja. Enega od projektov nam je predstavil 29-letni bioinformatik Nace Kranjc, ki dela v skupini znanstvenikov v londonskem laboratoriju.

Igranje na strunah borbenosti
Za Izolčanko Vido Rudolf sem slišala, ko sem se dogovarjala za pogovor z gospodom, ki izdeluje violine. Vida je namreč njegova stranka. »Kaj, nemogoče,« sem se odzvala na dejstvo, da gre za 31-letno violinistko, ki je strastna boksarka, njen trener pa je Dejan Zavec!? Vida Rudolf je te dni Sloveniji prinesla zlato medaljo, zdaj pa se pripravlja na evropsko prvenstvo v Španiji.

V Piranu aretirali Kanadčana, oboroženega s ponvijo in kuhinjskim nožem
Kanadčan, ki so ga včeraj pridržali v Piranu, je pristal na psihiatriji.

Fotografija je OSUPNILA MNOGE: Ne boste verjeli, kje se nahaja VROČI DE LIGT in kaj počne! (foto)
Eden najbolj vročih igralcev za hit se je pojavil na treningu Ajaxa.




Trump in Macron spet o Iranu
Bela hiša je sporočila, da se je predsednik ZDA Donald Trump v ponedeljek s francoskim kolegom Emmanuelom Macronom po telefonu pogovarjal o Iranu oziroma iranski grožnji, da poveča proizvodnjo oplemenitenega urana.
Prihodnost zdravja in lepote
Matične celice za obnovo telesa znanstveniki učinkovito pridobivajo tudi iz maščobnega tkiva.


Ajax s svojim ZVEZDNIKOM podpisal NEVERJETNO POGODBO, ostal bo kar - pozor - SEDEM LET!!!
Dušan Tadić ostaja zvest Ajaxu.

FOTO: Med igro z dedkom s križarke v smrt padlo 19-mesečno dete
V portoriškem pristanišču San Juan se je v nedeljo pripetila tragedija, v kateri je življenje izgubila še ne dve leti stara deklica.

Tina Gorenjak osupnila z najstniškim telesom
47. rojstni dan je proslavila s skokom v morje in oboževalce osupnila s podobo, ki si spominja na mlado dekle …

Ne upamo si zaropotati (zato pa delajo z nami kot svinja z mehom)
Služba je zamenjala družino, zato se je tudi nasilje preselilo tja.

Meghan Markle naj bi dobila kolumno v ugledni reviji
Vogue si vojvodinjo Sussekško želi za kolumnistko. Pogovori že potekajo.

Ne moreš jesti, če si sit
Poletje je čas, ko skoraj vsi, eni bolj, drugi manj, brezglavo hujšamo ne le zaradi videza v kopalkah, ampak predvsem zaradi počutja. Ko je vroče, nam je vsak korak odveč in vsak kilogram preveč.

Ali obstajajo afrodiziaki?
Težave v spolnosti so stare kolikor človeštvo. Zato so na srečo toliko stare tudi rešitve in mnoge med njimi so temeljito preverjene.

NAVELIČAL se je Slovenije in se vrnil - NAZAJ DOMOV! Nov odhod iz PLTS, prvoligaš ostal brez POMEMBNEGA ČLENA
Nov odhod iz Prve lige Telekom Slovenije.

Bernie Ecclestone bi umrl za Putina, želi si ga na čelu Evrope: "Nisem podpornik demokracije. Potrebujemo diktatorja"
Nekdanji šef formule 1 je prepričan, da je ruski predsednik eden od dobrih fantov in da ni dal ukaza za poskus atentata na Skripalove.

Kakšna TRAGEDIJA! Uresničila SANJE, ko se je NEDOLŽNA ZABAVA končala s SMRTJO! Podrobnosti osupnejo
Na Poljskem se je zgodila nova športna tragedija.

FOTO: V požaru v Mengšu zgoreli šotor, stroji za barvanje cest in kombi
Gasilci so morali v trdi noči posredovati v Mengšu, kjer je zagorelo skladišče.

VELIKO RAZKRITJE! Olimpija brez KLJUČNE OKREPITVE, potem ko se je izkazalo, da sploh ni …
Bo napovedan prestop padel v vodo?

ŽELEZNI kapetan je preprosto NEUNIČLJIV in hkrati … ZVEST! Gesta Boštjana Cesarja navdušila navijače (foto)
Slovenska legenda bo še podaljšala izjemno kariero.

BOMBA Z JUGA! Luka Zahović dobil NOVEGA SNUBCA, odmevajo besede, da bi bil to prestop, ki bi …
Luka Zahović je dobil novega snubca.

Ste videli tole?! To je Maribor! Takole so se OBLEKLI trenerji prvoligašev, Milanič IZRAZITO IZSTOPAL (foto)
Na Brdu pri Kranju so se zbrali trenerji slovenskih prvoligašev.



RAZKRITJE Primoža Peterke! Da so me Turki ZARADI ALKOHOLA ODPUSTILI? Tu je VSA RESNICA!
Oglasil se je Primož Peterka.


Stroški domov za starejše rastejo hitreje od prihodkov
Domovi za starejše in posebni socialnovarstveni zavodi tožijo Zavod za zdravstveno zavarovanje Slovenije (ZZZS).

Meghan in Harry sta imela zasebni krst sina
Čeprav se je dolgo ugibalo, kdaj točno bo mali Archie Harrison doživel svoj krst, sta kraljeva zakonca vseeno presenetila z dogodkom, ki se je zgodil minuli vikend.

Dnevni horoskop: Ne iščite podpore pri nezanesljivih ljudeh
Preverite, kaj vam za danes napovedujejo zvezde. Saj veste, dobro je biti pripravljen, pa naj teče beseda o dobrih ali nekoliko slabših rečeh.


(FOTO) Jubilejni kolesarski maraton po občini Moravske Toplice
Občinska športna zveza Moravske Toplice je organizirala 25. rekreativni kolesarski maraton po občini Moravske Toplice – Terme 3000. Udeležilo se ga je 96 kolesarjev.

(FOTO) Kar 17 mladih ribičev taborilo ob Bukovniškem jezeru
Ob Bukovniškem jezeru je kraparska sekcija iz Ribiške družine Lendava pripravila 3. Otroški kraparski tabor.

Ptuj: Med viteze naenkrat kar trije krvodajalci
Območno združenje Rdečega križa Ptuj se lahko pohvali s kar 37 vitezi krvodajalstva – krvodajalci, ki so kri darovali stokrat. Dosedanjim so se minuli teden pridružili kar trije. Sočasno so darovali kri in se vpisali na ta izjemni seznam vitezov. Gre za enkraten in poseben dogodek, ki se je zgodil prvič.


Dornava: Županove petice za najboljše učenke
Župan občine Dornava Janko Merc je po koncu šolskega leta na sprejem povabil dekleta, ki so se v času osnovnošolskega izobraževanja izkazala z izjemnimi uspehi.

Ptuj: Slovensko središče vizualne umetnosti
V svoji 17. izvedbi se festival sodobne vizualne umetnosti Art Stays, ki bo trajal do 12. julija, spogleduje z izzivi prihodnosti, umetniki se v sebi lastni izrazni obliki posvečajo prihodnosti in skušajo v svojih raziskovanjih odgovoriti na vprašanje: Kaj nas čaka?


Morda pa bi imeli raj na Zemlji ...
Kako veš, kakšen je raj, če nisi doživel pekla? Nikola Tesla, eden najslavnejših znanstvenikov vseh časov, je pekel izkusil večkrat – v otroštvu je bil dvakrat na robu smrti, bil je priča dvema svetovnima vojnama, s svojimi izumi je doživljal vzpone do neba pa tudi padce na dno, med fizične delavce.

Andreja Novak: Horoskop od 9. 7. do 15. 7. 2019
Včeraj je začel Merkur svojo retrogradno pot v Levu, ki jo bo zaključil 1.8. v znamenju Raka, kar pomeni, da vse, kar do sedaj še niste uspešno izrazili in / ali razmislili glede svojih čustev in vsega, kar se dogaja v odnosih, boste v tem obdobju obžalovali, da niste prej izrekli in uredili.